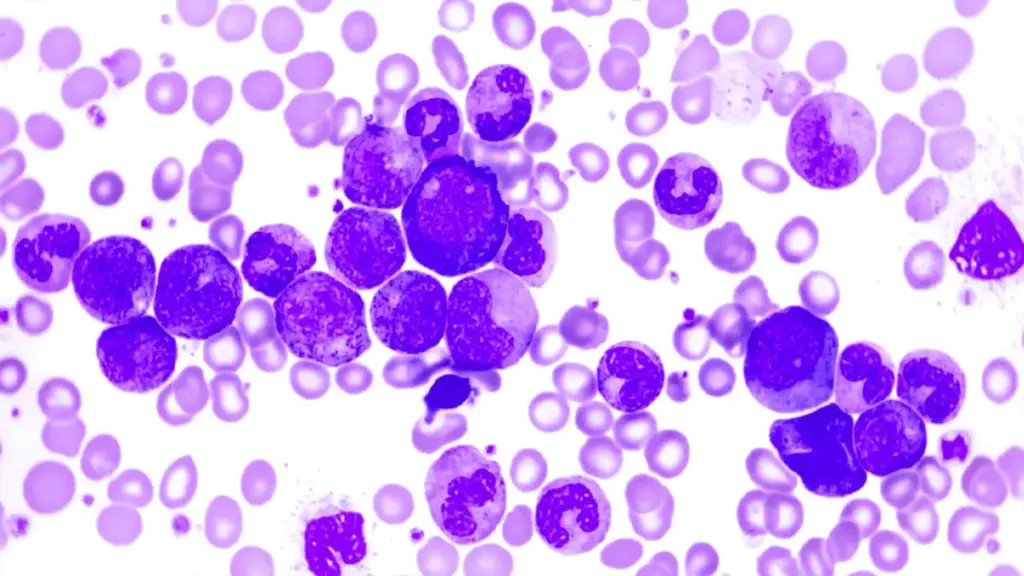

El mieloma múltiple es un tipo de cáncer que afecta a la sangre y tiene un pronóstico muy negativo.
Como sabemos, en ocasiones lo que parece una molestia puntual o irrelevante resulta ser un signo de un problema físico verdaderamente grave. Éste es el caso del mieloma múltiple, un cáncer que puede ser confundido con un dolor de espalda de carácter inespecífico.
En este artículo analizaremos qué es el mieloma múltiple, cuáles son sus síntomas típicos y cómo se aplica el tratamiento médico en estos casos -que en la actualidad siguen siendo incurables, si bien al menos es posible aliviar el malestar de forma significativa.
¿Qué es el mieloma múltiple?
El mieloma múltiple es un tipo de cáncer que afecta a la sangre. En concreto, consiste en la producción de cantidades anormalmente grandes de células plasmáticas. Dado que estas son las encargadas de crear los anticuerpos o inmunoglobulinas, fundamentales en la eliminación de virus, infecciones y otros agentes nocivos externos, este tipo de molécula también se concentra en la sangre en cantidades inusualmente elevadas.
Además las células de plasma cancerosas se acumulan en los huesos y en la médula, donde expulsan a otras células sanas y provocan la disolución de las estructuras óseas; esto último se debe a la secreción de determinadas proteínas.
La relación con la médula ósea es particularmente importante, y de hecho “mieloma” significa “tumor en la médula”. A medida que la enfermedad progresa las células cancerosas se expanden desde la médula al resto del organismo, provocando lesiones cada vez más graves en los órganos. El hígado se ve afectado con mucha frecuencia.
El mieloma múltiple está relacionado con la leucemia y el linfoma. El primero es un tipo de cáncer que consiste en una proliferación excesiva de glóbulos blancos (leucocitos), mientras que el término “linfoma” hace referencia a la afectación del sistema inmunitario; dos subtipos de linfoma muy frecuentes son el de las células T y el de las B, que son dos clases de glóbulo blanco.
Factores de riesgo y pronóstico
Entre los principales factores de riesgo que han sido asociados al mieloma múltiple cabe destacar el consumo excesivo de alcohol, la obesidad o la exposición a la radiación, así como ser varón, tener más de 65 años, ser negro y tener antecedentes familiares de esta enfermedad, de plasmocitoma óseo solitario o de gammapatía monoclonal de significado incierto (GMSI).
Según un informe publicado en la revista Lancet (2016) y basado en un macroestudio mundial, el mieloma múltiple causa alrededor de 100 mil muertes cada año. Se cree que la enfermedad se da en aproximadamente el 0,7% de la población en algún momento de la vida, sobre todo a partir de los 61 años.
Síntomas y signos principales
Si bien los síntomas del mieloma múltiple pueden variar en gran medida en función de la localización de los daños, se considera que los más representativos son el dolor de huesos, la anemia, los problemas renales, las infecciones oportunistas y ciertos signos neurológicos.
Como sabemos, el signo más característico del mieloma múltiple es el dolor en la columna y en las costillas, derivado de la acumulación de células cancerosas en esta región del sistema esquelético, que destruye parcialmente el tejido óseo. Es por esto que en ocasiones se dice que el mieloma se puede confundir con dolor de espalda no complicado.
La anemia surge como consecuencia de la producción anormal de glóbulos rojos, mientras que los problemas en los riñones se deben a las proteínas secretadas por dichas células cancerosas.
En cuanto a las infecciones, las más comunes son la neumonía y la pielonefritis (un tipo de infección de los riñones de origen bacteriano). Finalmente, los signos neurológicos más típicos incluyen los dolores de cabeza, la debilidad muscular, el cansancio o la sensación de confusión, aunque pueden aparecer otros más severos con el progreso de la enfermedad.
Tratamiento de este tipo de cáncer
A pesar de los avances que se han realizado en el tratamiento de los distintos tipos de cáncer, lo cierto es que en la actualidad el mieloma múltiple no tiene cura. Las terapias que se aplican a los pacientes afectados con esta enfermedad son de tipo sintomático y también son efectivos para reducir la velocidad con que progresa el cáncer.
Sin tratamiento, la esperanza de vida de las personas que han desarrollado un mieloma múltiple se encuentra alrededor de los 7 meses; en cambio, la mitad de los pacientes sobreviven al menos 5 años si se someten a una terapia.
Los métodos de intervención que se aplican en estos casos son variados. El tratamiento de elección es la quimioterapia, en particular en los casos que se dan antes de los 65 años. En los últimos años se ha empezado a utilizar el trasplante de células madre y, si bien los resultados son prometedores, por el momento no se trata de una cura definitiva.
La radioterapia también se emplea con frecuencia para aliviar los síntomas de dolor que se producen en los huesos a causa de los daños derivados del mieloma. El trasplante de médula ósea es otro de los procedimientos más relevantes en este campo.
Referencias bibliográficas:
Raab, M. S., Podar, K., Breitkreutz, I., Richardson, P. G. & Anderson, K. C. (2009). Multiple myeloma. Lancet, 374(9686): 324–39.
GBD 2015 Mortality and Causes of Death, Collaborators (2016). Global, regional, and national life expectancy, all-cause mortality, and cause-specific mortality for 249 causes of death, 1980-2015: A systematic analysis for the Global Burden of Disease Study 2015. Lancet, 388(10053): 1459–1544.
GBD 2015 Disease and Injury Incidence and Prevalence, Collaborators. (2016). Global, regional, and national incidence, prevalence, and years lived with disability for 310 diseases and injuries, 1990-2015: A systematic analysis for the Global Burden of Disease Study 2015. Lancet, 388(10053): 1545–1602.